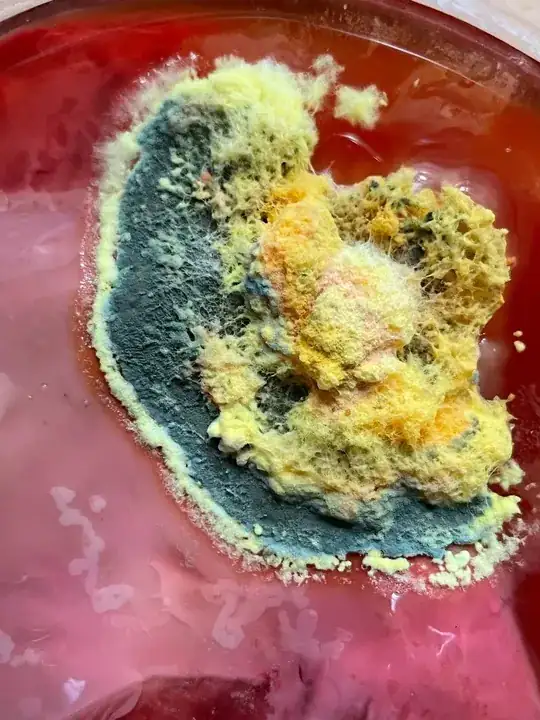
enter image description here

I found this mold in my new vinegar batch. It has grown in the second refill of alcoholic soda when the mother of vinegar was already formed. Does anyone know why this mold has come out in the vinegar?
Thank you for your help.
.
Asked
Active
Viewed 386 times
1
Joe
- 78,818
- 17
- 154
- 448
Sonia D.B.
- 11
- 3
1 Answers
0
Probably the pH was not low enough and/or the sugar content was too high. The recommended way to make vinegar has 2 steps:
- turning the sugars into alcohol through yeast: this is an anaerobic process, so mold should not be a problem (mold needs oxygen) if you install the airlock properly (note: the link above does not mention the airlock, but I highly recommend it, this video explains why)
- turning the alcohol into vinegar: at this point there should not be any sugar left in the liquid, otherwise at the start when the pH is not low enough, molds can form. This is an aerobic process because the acetic acid bacteria need oxygen
There is one more reason to use this process: if you do not have a separate step for the alcoholic fermentation, you will never know, when it is finished. If you bottle an unfinished batch, the alcoholic fermentation might continue, causing the bottle to explode (you could injure yourself). This should not be the case for unfinished vinegar fermentation, because the AAB run out of oxygen.
G. B.
- 752
- 4
- 11
-
Thank yoy GB for your answer. I forgot to explain that this vinegar is made of Cinzano bitter soda, a beverage with a 8.5% vol alc, so the first step of fermentation to get alcohol is not needed. As you said, at this point there should not be any sugar left in the liquid, and there was sugar and caramel added in it. Probably that has been the problem. In the first batch the vinegar was succesfully created and I followed the same process in the second batch, thats why didn’t understand what failed. Even with an 8.5% vol alcohol, this molds can appear? Thank you again – Sonia D.B. Oct 25 '21 at 08:17
-
Thank you for the clarification. I updated the answer, then lost the changes when I signed in. Shortly: cinzano bitter contains sugar and sulphites, which does not favour the AAB when they have to compete against mold. Why your first batch succeeded, I can't say, maybe you had luck. To get rid of the sulphites, you could use some polymer wine filters, like Üllo or some say hydrogen peroxide also converts the sulphites to something less harmful. Then you could start the alcoholic fermentation by adding yeast and after that kick-start the AA fermentation by adding some of the old/live vinegar. – G. B. Oct 26 '21 at 12:33